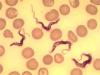
Паразиты научились разрывать свою ДНК для обмана иммунной системы

отметили
3
человека
в архиве
Американские митинги с горячим чаем
 rg.ru
rg.ru
К 15 апреля американцы подают документы о своем подоходном налоге федеральному правительству и властям штатов. В нынешнем году многие граждане выбрали эту дату, чтобы выразить свое негативное отношение к росту налогов и расточительству федерального бюджета.
Прокатившиеся по всей стране митинги б...
1 комментарий
проблема (2)
отметили
85
человек
в архиве
Семь стран Латинской Америки утвердили соглашение о введении собственной денежной единицы.
 rian.ru
rian.ru
Страны-участницы Боливарианской инициативы для Америк (ALBA) на саммите этой организации в венесуэльском городе Кумана единогласно утвердили соглашение о введении условной единицы взаиморасчетов "сукре", сообщает РИА Новости.
По словам президента Венесуэлы Уго Чавеса, сукре изначально ...
отметил
1
человек
в архиве
Самый мощный усилитель в мире из Новой Зеландии
 audiomania.ru
audiomania.ru
Не очень известный, но гордый производитель из Новой Зеландии с французским названием "Perreaux" заявил на днях, что ему удалось сделать самый мощный интегральный усилитель в мире. 350 Ватт на канал в классе AB — это действительно немало. Но самое интересное — это наличие в усилителе USB р...
проблема (3)
отметили
19
человек
в архиве
МВФ: Спад экономики будет необычно глубоким и длительным
 vedomosti.ru
vedomosti.ru
Экономический спад, спровоцированный текущим мировым финансовым кризисом, будет глубже и длительнее, чем предыдущие — таков основной вывод регулярного доклада экспертов Международного валютного фонда «Обзор перспектив мировой экономики». По мнению экспертов, к этому ведет сочетание финансового кризи...
отметили
26
человек
в архиве
Антикризисные меры РФ и Украины признаны самыми неэффективными
 top.rbc.ru
top.rbc.ru
Антикризисные меры правительств Украины и России наименее результативны. К такому выводу, как пишет сегодня газета РБК-daily, пришли эксперты аудиторской компании ФБК, рассчитавшие Индекс антикризисной эффективности для восьми стран.
Самими успешными в борьбе с кризисом признаны Великобрита...
отметили
19
человек
в архиве
МИД Японии отверг вариант раздела Южных Курил напополам с РФ
 vz.ru
vz.ru
Министр иностранных дел Японии Хирофуми Накасонэ отверг сегодня инициативу одного из ближайших советников премьер-министра страны, который предложил урегулировать вопрос о Южных Курилах путем раздела этих островов с Россией напополам.
«Нет никаких изменений в курсе правительства на то, чтоб...
отметили
56
человек
в архиве
YouTube достиг соглашения о показе фильмов от Sony Pictures, MGM и других кинокомпаний
 cybersecurity.ru
cybersecurity.ru
Интернет-сервис сервис YouTube достиг лицензионного соглашения с кинокомпаниями Sony Pictures, Metro Goldwyn Mayer и телекомпанией CBS на показ в интернете в потоковом режиме их контента, в том числе фильмов и записей телевизионных программ. Сообщение об это появилось в официальном блоге YouTube.
...
отметили
18
человек
в архиве
Страсбургский суд впервые обсудил иск Грузии против России: решение не принято
 korrespondent.net
korrespondent.net
Европейский суд по правам человека (ЕСПЧ) в Страсбурге провел первое заседание по иску Грузии, обвиняющей Россию в нарушении прав грузинских граждан из-за якобы имевших место "произвольных арестов и массовых депортаций" с российской территории в 2006-2007 годах.
Решение по приемлемости...
отметили
3
человека
в архиве
Министерство юстиции Беларуси приостановило решение об отказе регистрации Партии Белорусская Христианская Демократия
 kazulin.info
kazulin.info
На сайте Министерства юстиции Беларуси появилось сообщение о приостановлении решения Министерства юстиции об отказе в государственной регистрации Партии Белорусская Христианская Демократия.
Как сообщалось ранее, группа христиан различных конфессий (1055 человек) 12 марта 2009 подали в Минюст док...
проблема (3)
отметили
21
человек
в архиве
ЦИК Молдавии добралась до необработанных бюллетеней: коммунисты потеряли 1 мандат и не смогут избрать президента
 regnum.ru
regnum.ru
По последним представленным данным, показатель Партии коммунистов снизился — ПКРМ получает 49,90% голосов. Либеральная партия набирает 12,80% голосов, Либерально-демократическая партия — 12,30, Альянс "Наша Молдова" — 9,80%. В соответствии в этими данными, коммунисты могут получить в парла...
отметили
21
человек
в архиве
Фурсенко предложил экзаменовать выпускников вузов
 infox.ru
infox.ru
Глава Министерства образования и науки Андрей Фурсенко предложил допускать молодых юристов к практике не раньше, чем они сдадут квалификационные экзамены, сообщает РИА «Новости». По результатам этих экзаменов будут также судить и о качестве обучения в вузах и принимать решение о продлении лицензии.
...
проблема (1)
отметили
17
человек
в архиве
Москва уже никогда не согласится рассматривать Грузию единой страной: Саакашвили
 regnum.ru
regnum.ru
Москва уже никогда не согласится рассматривать Грузию единой страной со своими исконными территориями — Абхазией и Южной Осетией, заявил в Тбилиси президент Грузии Михаил Саакашвили.
"Я слышал о том, что Москва готова вести переговоры с Грузией, если тут будет новая власть. Но хочу зав...
отметили
16
человек
в архиве
Юридические вузы попадут под десятикратное сокращение
 kommersant.ru
kommersant.ru
На заседании Ассоциации юристов России с участием президента Дмитрия Медведева обсуждалась реформа юридического образования, призванная решить проблему перепроизводства юристов. В первую очередь речь шла о введении дополнительных экзаменов по профессии перед приемом на работу и создании перечня юрид...
проблема (1)
отметили
17
человек
в архиве
В финале Кубка УЕФА будет играть одна из двух ведущих украинских команд.
 podrobnosti.ua
podrobnosti.ua
Донецкий "Шахтер" стал соперником киевского "Динамо" в полуфинале Кубка УЕФА, выиграв в Марселе на "Велодроме" у местного "Олимпика" 2:1.
p.s. Пояснение от меня: это произошло благодаря тому, что Динамо (Киев) выиграло у французского же ПСЖ 3:0. В общ...
проблема (2)
отметили
59
человек
в архиве
Первая в мире космическая электростанция будет построена в Калифорнии
 techvesti.ru
techvesti.ru
На днях калифорнийская энергетическая компания Pacific Gas and Electric (PG&E) подписала соглашение с небольшой корпорацией Solaren, о том чтобы совместными усилиями обеспечить добычу к 2016 году около 200 МВТ энергии, получаемой из космоса и передаваемой на землю. Суть проекта в размещении на геост...
отметили
27
человек
в архиве
17 апреля исполняется 115 лет со дня рождения Никиты Хрущева
 ru.wikipedia.org
ru.wikipedia.org
Никита Сергеевич Хрущёв родился 17 апреля 1894 года. Первый секретарь ЦК КПСС с 1953 по 1964 годы, Председатель Совета Министров СССР с 1958 по 1964 годы. Герой Советского Союза, Трижды Герой Социалистического Труда. Первый лауреат Шевченковской премии.
Развенчал культ личности Сталина, про...
проблема (7)
отметили
6
человек
в архиве
Сборная России выиграла Евротур
 gazeta.ru
gazeta.ru
Сборная России, которой для общей победы в Евротуре нужно было добыть очко в матче с финнами, уступила им в Тампере со счетом (2:4). Однако чехи, выиграв позднее у шведов, помогли в этом российской сборной
проблема (1)
отметили
37
человек
в архиве
Россия призывает НАТО отменить учения в Грузии
 inosmi.ru
inosmi.ru
Россия призвала НАТО отменить запланированные на май учения на территории Грузии. По ее мнению, их проведение идет вразрез с усилиями по восстановлению связей между Москвой и альянсом.
Как сообщают представители НАТО, в маневрах на территории Грузии — бывшей советской республики, которой в ...
проблема (1)
отметили
93
человека
в архиве
Хакеры научились расшифровывать PIN-коды кредитных карт habrahabr.ru
пециалисты продолжают удивляться, как хакеры умудряются начать практическое использование методов, которые ещё год назад признавались только теоретически возможными, да и то в узкой академической среде. Теперь они научились снимать PIN-коды с наших карточек, не проникая непосредственно в банкомат, к...
отметили
7
человек
в архиве
Мурманскую молодежь могут лишить Года молодежи!
 kva-v-kube.livejournal.com
kva-v-kube.livejournal.com
16 апреля стало известно, что Управление по делам молодежи Мурманской области не включено в структуру нового областного Правительства.
В связи с этим целый ряд крупномасштабных молодежных мероприятий региона находится под угрозой срыва или исчезновения.
Зачем нужны такие перемены? ...
проблема (9)
отметили
19
человек
в архиве
Астрономы разглядели самое гигантское "ДТП" во Вселенной
 rian.ru
rian.ru
Ученые с помощью данных с трех телескопов смогли впервые зафиксировать и в деталях изучить процесс столкновения сразу четырех скоплений галактик — самых больших объектов во Вселенной, связанных гравитацией и способных двигаться как единое целое.
Используя данные с рентгеновской орбитальной ...
проблема (1)
отметили
26
человек
в архиве
Абхазия не собирается просить признать ее независимость. "Мы сами должны создать такую ситуацию в своей республике - экономическую и политическую стабильность, единство нации - для того, чтобы ни...
 izvestia.ru
izvestia.ru
Условием для признания независимости Абхазии в мире является укрепление экономической и политической стабильности в самой стране, заявил президент республики Сергей Багапш. "Мы не будем никого просить признавать республику Абхазия. Мы сами должны создать такую ситуацию в своей республике — экон...
отметили
18
человек
в архиве
The Guardian о новом Центре киберзащиты НАТО в Эстонии: еще 20 лет назад это казалось фантастикой
 inopressa.ru
inopressa.ru
Корреспондент The Guardian Бобби Джонсон одним из первых побывал на новой военной базе Североатлантического альянса, расположенной на окраине Таллина. Официально она называется Совместный центр по обеспечению безопасности в киберпространстве, но здесь ее называют обычно просто К-5, пишет InoPressa.r...
отметили
76
человек
в архиве
Где границы морали и нравственности? Самозахваты крымских татар достигли военных кладбищ: на могилах солдат строят дома и мечети.
 newsru.com
newsru.com
Скандал с самозахватом земель крымскими татарами под Симферополем приобрел международный масштаб. Меджлисовские "поляны протеста" в совхозе "Красный" строят прямо на могилах погибших в годы Второй мировой солдат.
Как пишет "Крымское Эхо", на окраине поселка Мир...
проблема (1)
отметили
18
человек
в архиве
Президент Дмитрий Медведев считает, что Москве необходимо создать свой Гайд-парк для проведения мирных собраний и шествий
 polit.ru
polit.ru
Президент РФ Дмитрий Медведев считает, что в Москве необходимо создать свой "Гайд-парк" для проведения мирных собраний и шествий.
"Нужно поговорить с московскими властями, пусть создадут свой "Гайд-парк", те же самые деревья посадят и так далее", — заявил Медведев н...
отметили
24
человека
в архиве
Паразиты научились разрывать свою ДНК для обмана иммунной системы
 lenta.ru
lenta.ru
Паразиты Trypanosoma brucei, вызывающие сонную болезнь, избегают воздействия иммунных клеток организма-хозяина, перестраивая свою ДНК. Статья ученых, сделавших это открытие, опубликована в журнале Nature. Коротко исследование описано в пресс-релизе Рокфеллеровского университета.
Сонная болезнь —...
отметили
8
человек
в архиве
Под лозунгом "90 лет работы во имя социальной справедливости" отметит свой юбилей Международная организация труда
 ami-tass.ru
ami-tass.ru
Правительства, объединения работников и работодателей по всему миру, представляющие 182 государства – членов Международной организации труда /МОТ/, будут отмечать 90-летие организации. Как сообщается в пресс-релизе, распространенным Штаб-квартирой МОТ в Женеве, в течение недели начиная с 21 апреля п...
отметили
11
человек
в архиве
Активист "Наших" пожаловался на пытки в грузинской полиции
 lenta.ru
lenta.ru
Активист "Наших" Александр Кузнецов отказался от своих показаний, записанных на видеокамеру грузинской полицией. Об этом сообщает "Интерфакс" в четверг, 16 апреля.
Кузнецов связался с "Интерфаксом" по телефону из Тбилиси и заявил: "Меня били и заставляли н...
проблема (1)
отметили
5
человек
в архиве
Минюст Беларуси отказал в регистрации Партии Белорусская христианская демократия
 kazulin.info
kazulin.info
Поводы отказа будут озвучены на пресс-конференции 16 апреля в минской штаб-квартире, сообщил сопредседатель БХД Павел Северинец.
Как сообщалось ранее, оргкомитет БХД выполнил все необходимые формальности. Было собрано 1055 подписей учредителей. Учредительный съезд БХД прошел 28 февраля. На нем п...
проблема (3)
отметили
75
человек
в архиве
Таджик зачистил скинхедов
 gazeta.ru
gazeta.ru
Гражданин Таджикистана объявлен в международный розыск за убийство скинхедов в Подмосковье. Националисты отлавливали гастарбайтеров в электричках и избивали, но встретили неожиданный отпор. 26-летний Саиджон Раджабов зарезал троих скинхедов и уехал на родину.
… ...
проблема (3)